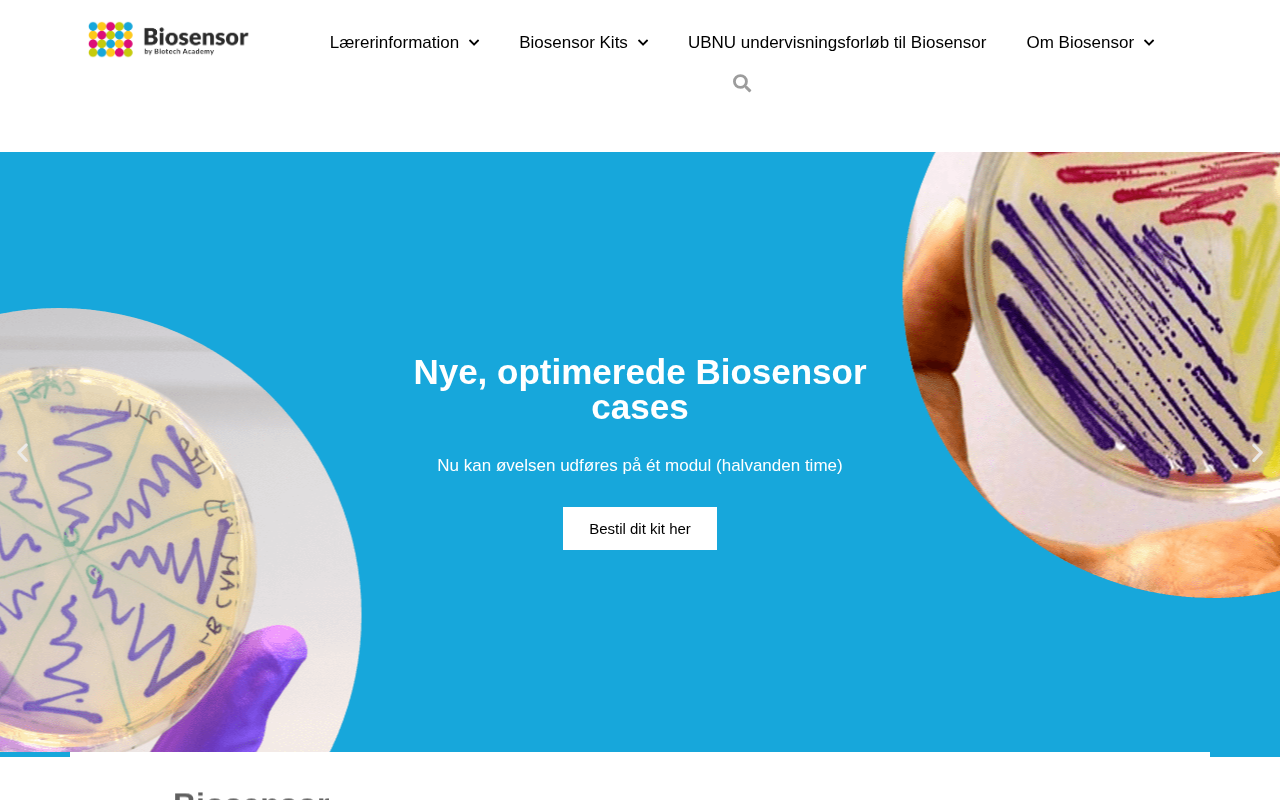

biosensor.dk
| captured | 2026-01-23T03:23:57 |
| status | ok |
| first seen | 2026-01-16 |
| last seen | 2026-03-22 |
whois
| registrant | Danmarks Tekniske Universitet → 101 domains | ||||||||||||||||
| address | Anker Engelunds Vej 101 → 101 domains | ||||||||||||||||
| postal | 2800 Kongens Lyngby → 2674 domains in 2800 | ||||||||||||||||
|
top addresses in 2800
|
|||||||||||||||||
| country | DK | ||||||||||||||||
| created | 2016-06-14 | ||||||||||||||||
| expires | 2026-06-30 | ||||||||||||||||
| servers |
ns.dandomain.dk ns2.dandomain.dk |